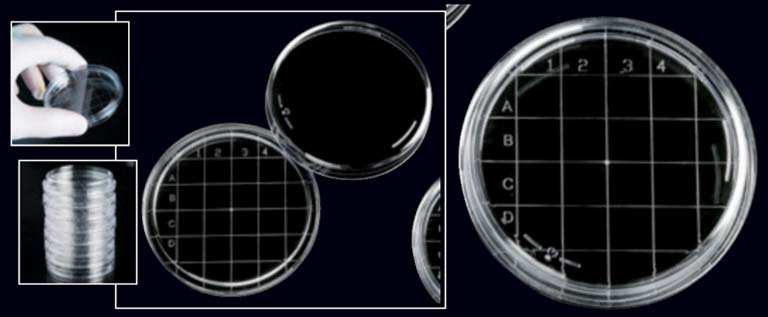

Placas de contacto Rodac, estéril radiación, 65,7Ø x 14,7mm. caja 500ud. (25x20)

Placas concebidas para la industria farmacéutica y alimentaria así como en entornos hospitalarios para la determinación de contaminación bacteriana en superficies como la piel, salas de quirófano, cámaras refrigeradas y superficies de trabajo en general.
Fabricadas en poliestireno transparente.
La base posee una cuadrícula que hace posible identificar la muestra por cm2 y facilita el recuento de colonias.
Son apilables: La forma de la tapa hace que se puedan apilar y se mantengan estables durante el transporte e incubación.
Dimensiones de la placa: 65,7 mm x 14,7 mm de altura.
Estéril por radiación.
Cantidad: caja de 500 ud. (25 x 20 ud.)
Referencia: AU200218
Marca: Deltalab


